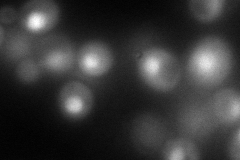
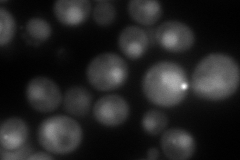
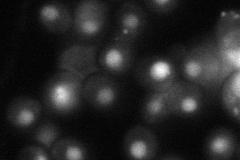
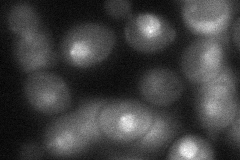

View description
Subunit of heterotrimeric Replication Protein A (RPA), which is a highly conserved single-stranded DNA binding protein involved in DNA replication, repair, and recombination
Localization:
Intensity:
Fold change:
Significance:
-
C’ GFP library in SD

below threshold17.11 -
N' NOP1pr-GFP in SD
punctate,nucleus170.551 -
N' TEF2pr-mCherry in SD
nucleus179.48 -
N' NATIVEpr-GFP in SD
punctate,nucleus54.1572 -
N' TEF2pr-VC and Cyto-VN in SD
punctate,nucleus53.7679 -
C’ GFP library in SD+DTT

cytosol13.220.77No -
C’ GFP library in SD+H2O2

cytosol20.311.18No -
C’ GFP library in Starvation Media

cytosol18.811.09No -
C’ GFP library on the background of Pup2-DaMP

below threshold -
C’ GFP library on the background of CCT mutant

below threshold20.50751.19797No
